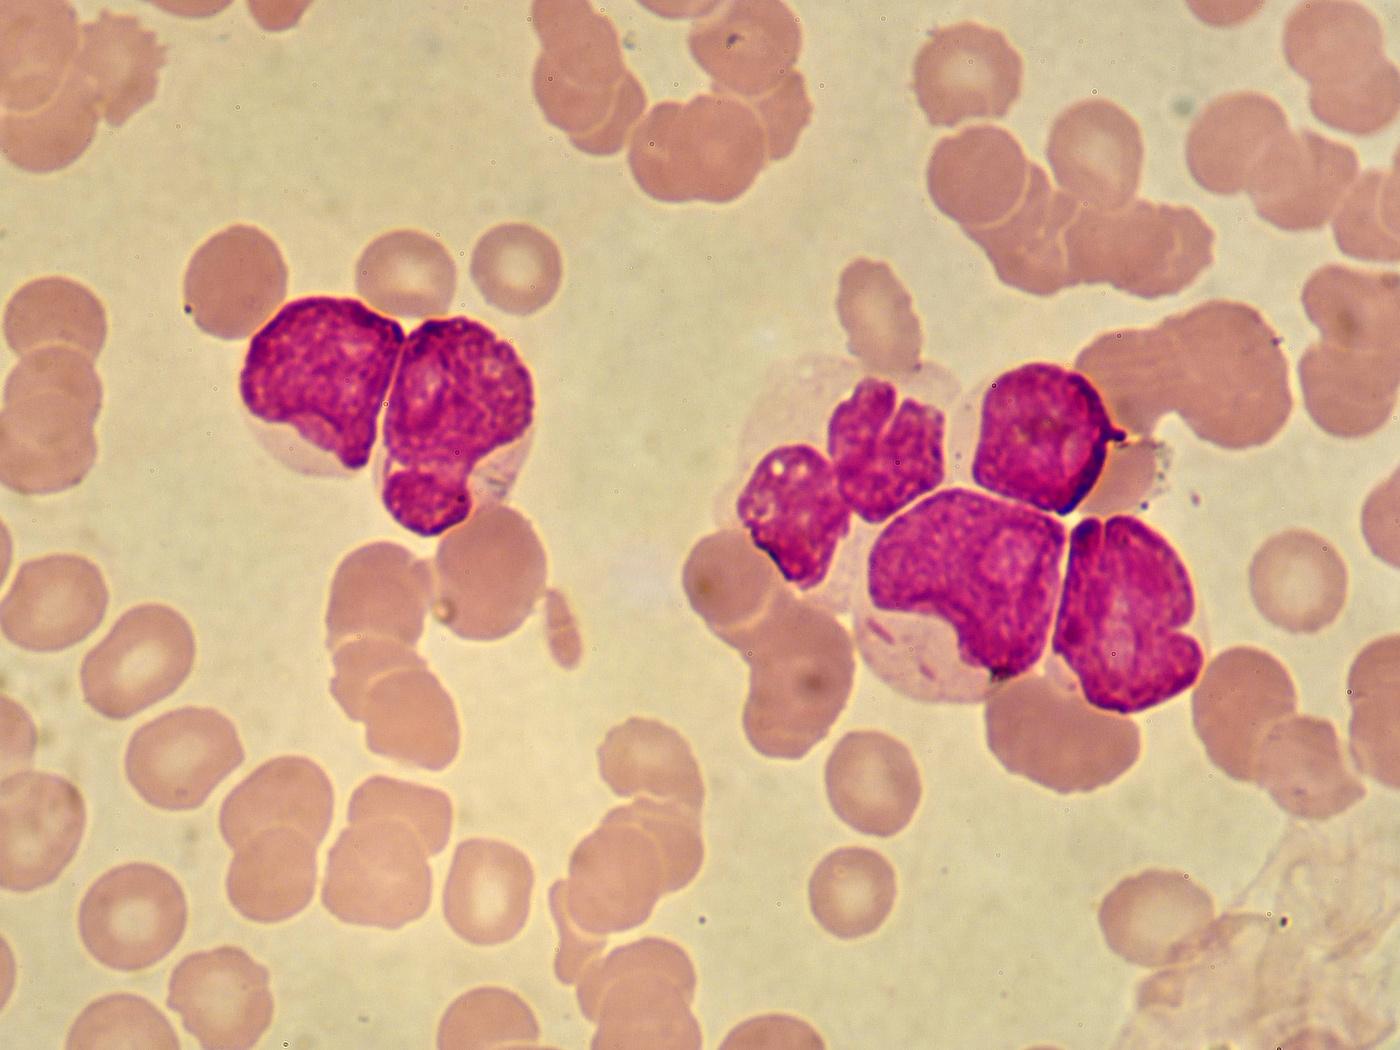
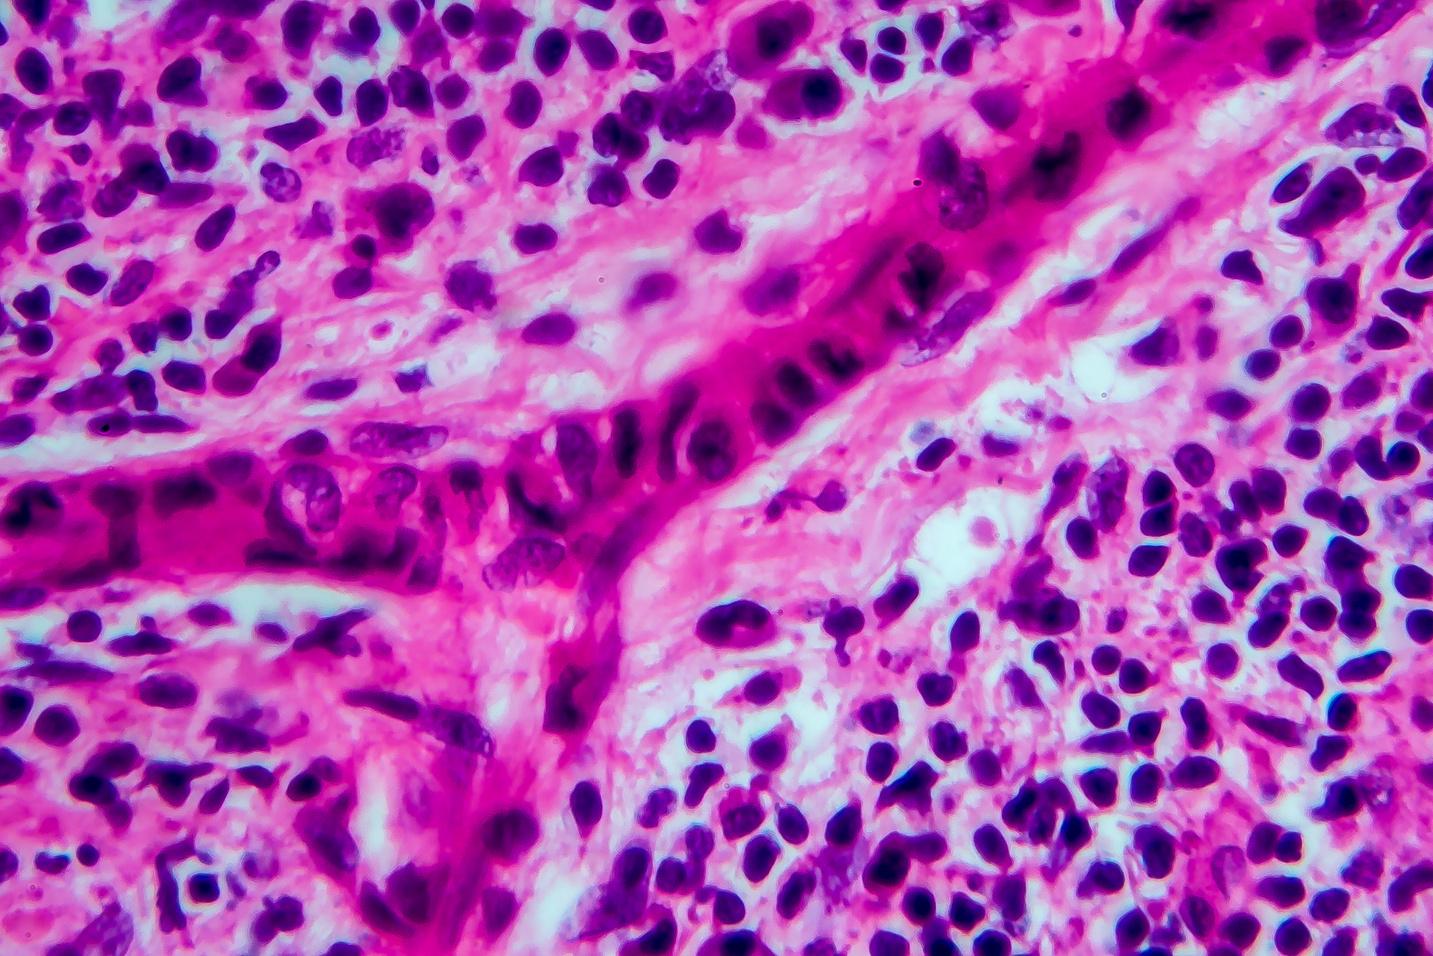

TYPES OF BLOOD CANCER
Dodul Mondal www.oncologistdrdodulmondal.com
Dr.
WhatIsBloodCancer?
Types
Non-HodgkinLymphoma
HodgkinLymphoma

MultipleMyeloma

INDEX
Leukemia
www.oncologistdrdodulmondal.com
What Is Blood Cancer?
Cancer begins in blood-forming tissue, such as the bone marrow, or in the cells of the immune system.
Blood cancer happens when something goes wrong with your blood cells. This stops them from working properly, and they may grow out of control.
Leukaemia, lymphoma, and myeloma are some of the most common types of blood cancer.


www.oncologistdrdodulmondal.com





LEUKEMIA HODGKIN LYMPHOMA NON-HODGKINLYMPHOMA MULTIPLEMYELOMA TYPES OF BLOOD CANCER www.oncologistdrdodulmondal.com
LEUKEMIA
Leukemia is a cancer of the body's blood-forming tissues, includingthebonemarrowandthelymphaticsystem.

Many types of leukemia exist. Some forms of leukemia are more common in children. Other forms of leukemia occur mostlyinadults.
Leukemiausuallyinvolveswhitebloodcells.Yourwhiteblood cells are potent infection fighters — they normally grow and divide in an orderly way, as your body needs them. But in people with leukemia, the bone marrow produces an excessiveamountofabnormalwhitebloodcells,whichdon't functionproperly.

www.oncologistdrdodulmondal.com
NON- HODGKIN LYMPHOMA

Non-Hodgkin'slymphomaisatypeofcancerthatbeginsinyour lymphatic system, part of the body's germ-fighting immune system. In non-Hodgkin's lymphoma, white blood cells called lymphocytes grow abnormally and can form growths (tumors) throughoutthebody.
Non-Hodgkin's lymphoma is a general category of lymphoma. Many subtypes fall into this category. Diffuse large B-cell lymphoma and follicular lymphoma are among the most common subtypes. The other general category of lymphoma is Hodgkin'slymphoma.

www.oncologistdrdodulmondal.com
HODGKIN LYMPHOMA

Hodgkin's lymphoma is a type of cancer that affects the lymphatic system, which is part of the body's germ-fighting immune system. In Hodgkin's lymphoma, white blood cells calledlymphocytesgrowoutofcontrol,causingswollenlymph nodesandgrowththroughoutthebody.
Hodgkin's lymphoma, which used to be called Hodgkin's disease, is one of two general categories of lymphoma. The otherisnon-Hodgkin'slymphoma.

www.oncologistdrdodulmondal.com
MULTIPLE MYELOMA

Multiplemyelomaisacancerthatformsinatypeofwhiteblood cell called a plasma cell. Healthy plasma cells help you fight infections by making antibodies that recognize and attack germs.
Inmultiplemyeloma,cancerousplasmacellsaccumulateinthe bone marrow and crowd out healthy blood cells. Rather than produce helpful antibodies, the cancer cells produce abnormal proteinsthatcancausecomplications.

www.oncologistdrdodulmondal.com
Thank you! www.oncologistdrdodulmondal.com

www.oncologistdrdodulmondal.com CONTACTUS DODULMONDAL@GMAIL.COM +91-8860-102-093 1,PRESSENCLAVEROAD,MAXSUPERSPECIALITY HOSPITAL,EASTBLOCK,SAKET,DELHI-110017